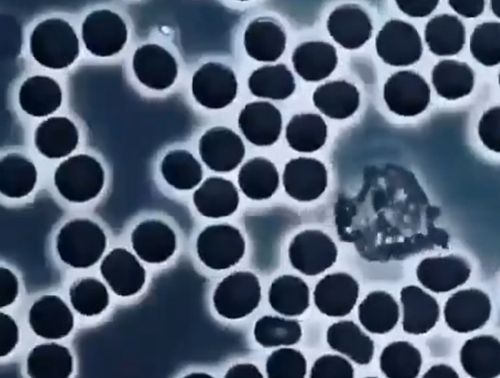

Решение всех проблем на поверхности






За квартиру за январь

Острый соус Бульдак понял свою аудиторию и начал выпускать буквально шедевральную рекламу об основной ценности своего продукта


Бедный пёсик начал переживать




Когнитивное управление массами.


Теперь вы можете купить шот для человека, указав его имя в напитке

А ее впустить некому, все заняты.

Каждый айтишник или просто техногик хотя бы раз думал: “А не купить ли мне 3D-принтер?” Потом считал деньги, представлял пыльный аппарат на полке и отказывался от идеи. А потом... снова ловил себя на том же. И ведь хочется! Особенно после очередной крутой самодельной штуковины в сети.



Как я умею!

Хотя, может быть именно эта песня у него в наушниках играет



Помните, как на уроках труда строгали табуретки и жгли паяльники? Сейчас всё как-то иначе. Современные школьники на таких уроках больше похожи на участников реалити-шоу: то ли делают, то ли делают вид. Вопрос открытый: это всё ещё полезный навык или уже архаика?
